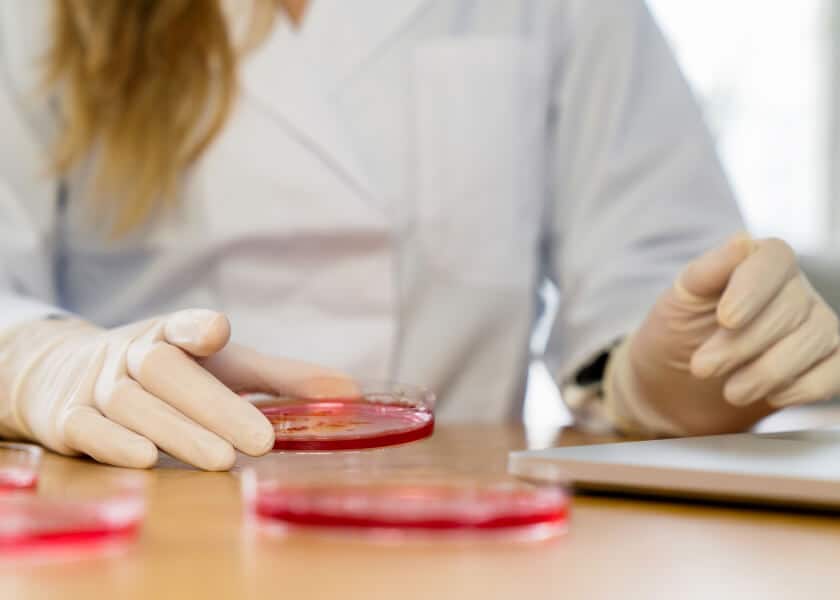
Person in a lab coat and gloves holding a petri dish with red substance on a table.

Professional and Continuing Education
Professional and Continuing Education Students Are Ready to Move Forward
Your next generation of learners is already balancing a full life. We’ll help you reach them with strategies that respect their time, goals, and potential.


Today’s Professional and Continuing Education Students Are Redefining Higher Ed
They’re balancing work, family, and ambition, seeking flexible, career-aligned programs that deliver measurable results fast.
Carnegie partners with colleges and universities to attract, enroll, and retain these learners through strategies that honor both their time and your institution’s mission. We connect outcomes to opportunity, helping you grow enrollment, strengthen reputation, and prove the ROI of lifelong learning.
Integrated Solutions That Empower Adult Learners and Strengthen Institutions
From brand to enrollment, Carnegie connects every part of your continuing education strategy. We help you reach working learners with clarity, relevance, and results, building pathways that drive growth, belonging, and long-term impact.
Build a Brand That Means Something to Working Learners
Your continuing education brand should inspire trust, confidence, and clarity. Carnegie uncovers your institution’s most human truths, then translates them into a brand story that resonates with adult learners and employers alike.
Meet Adult Learners Where They Are
We combine behavioral insights, psychographic segmentation, and precision targeting to reach adult learners on the platforms they trust most. Every campaign is built to capture attention, drive qualified inquiries, and deliver measurable ROI.
Turn Interest Into Enrollment Through Data and Personalization
Our predictive analytics, CRM integrations, and hyper-personalized outreach help institutions engage adult learners with clarity and confidence. From first inquiry to enrollment, we make the path frictionless, fast, and student-centered.
Support Adult Learners Beyond Enrollment
Working adults juggle complex lives. We help institutions design support systems—from advising to career development—that foster persistence and belonging, ensuring every student finishes what they started.
Institutional Strategy for Continuing Education
Carnegie partners with campus leaders to align programs, policies, and planning around the evolving needs of adult learners and employers. Together, we build strategies that expand access, strengthen community impact, and sustain growth.
Let’s Solve Your Continuing Education Challenges–Together
Why Institutions Choose Carnegie
Colleges partner with Carnegie because we understand what drives students and what drives you.
Our teams combine higher ed expertise, behavioral science, and AI-powered intelligence to design strategies that deliver meaningful results: stronger brands, higher yield, and measurable growth.

Human Insight, Powered by AI
We combine emotional intelligence with predictive analytics, data, and technology to reveal what truly moves students, and turn those insights into meaningful connection.
Integrated Solutions, One Partner
We design custom solutions that fit your unique needs and connect every stage of the student journey. From awareness to retention, we bridge marketing, enrollment, and strategy for a unified approach.
Proven Impact
Every project is measured by outcomes—enrollment growth, engagement gains, and institutional alignment.
Professional and Continuing Education Challenges We Help Solve
Proving Outcomes in a Crowded Credential Market
Show value that cuts through the noise.
Adult learners need proof that education will pay off. We help institutions spotlight program outcomes, employer relevance, and skill alignment, turning “maybe later” into “I’m ready now.”
Highlight your continuing ed value through an authentic, outcome-driven brand that builds employer and student trust.
Turn awareness into applications through predictive intelligence, tailored communication, and optimized engagement strategies.
See how one institution achieved a 48X return on a targeted digital campaign.
Removing Friction for Working Learners
Simplify the path to enrollment.
From one-sitting applications to fast credit evaluations, we help you build experiences that respect busy schedules and reduce barriers.
Streamline every step from inquiry to enrollment with predictive data, personalized messaging, and seamless technology integrations.
Integrate automation, workflows, and dashboards that make applying and enrolling faster for both students and staff.
See how one university increased request for information conversions by more than 700%.
Connecting Education to Work and ROI
Align every program with real-world outcomes.
We help institutions design and market offerings that map directly to in-demand skills, credentials, and career advancement.
Develop plans that connect programs to employer demand and workforce relevance.
Use labor-market data to refine program portfolios and strengthen partnerships with key industries.
See how one campus achieved nearly 26% total enrollment growth through strategic planning.
Let’s Solve Your Professional and Continuing Education Challenges
Featured CONTINUING EDUCATION Case Study
“Partnering with Carnegie has been a transformative experience for MUSC. Academic health science centers are inherently complex, but their team took the time to understand who we truly are.”
Mack Altman
Assistant Provost for Strategic Initiatives + Communications
Medical University of South Carolina
Insights for Institutions Serving Professional and Continuing Education Students
Let Us Help You Reach Professional and Continuing Education Students
Tell us a bit about yourself and we’ll be in touch shortly to start the conversation.